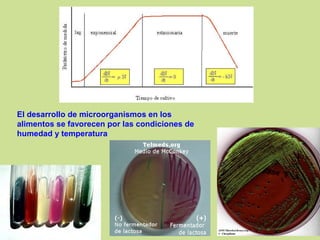
El desarrollo de microorganismos en los
alimentos se favorecen por las condiciones de
humedad y temperatura

Este documento describe varios métodos de conservación de alimentos, incluyendo procesos térmicos como la pasteurización y esterilización, secado, irradiación, refrigeración y congelación. Explica cómo estos métodos reducen la actividad de agua y destruyen microorganismos para prevenir el deterioro de los alimentos.